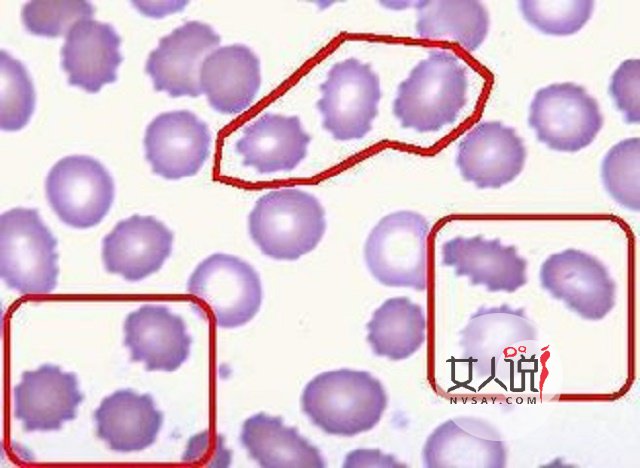
红细胞偏高?你还不知道是怎么了?快来看看有哪些原因吧

红细胞偏高要注意什么

1、在饮食上应注意低盐低脂,多食用高维生素食物;戒烟戒酒,忌食生冷辣性食物。 2、控制高蛋白食物的摄入以及有补血功能的食物,如红枣、红豆等。 3、养成良好生活作息习惯,适当进行体育锻炼,促进新陈代谢,增强抵抗力。

4、定期检查,以及时发现异常情况。 由于造成红细胞偏高的原因有很多,为了对诱因进行详细的排查,定期的身体检查是非常有必要的。平时饮食要多加注意,以清淡为宜,增加适当的运动,对身心健康都有很大益处。如有异常情况发生,要及时就医,以免耽误治疗。
1、在饮食上应注意低盐低脂,多食用高维生素食物;戒烟戒酒,忌食生冷辣性食物。 2、控制高蛋白食物的摄入以及有补血功能的食物,如红枣、红豆等。 3、养成良好生活作息习惯,适当进行体育锻炼,促进新陈代谢,增强抵抗力。

4、定期检查,以及时发现异常情况。 由于造成红细胞偏高的原因有很多,为了对诱因进行详细的排查,定期的身体检查是非常有必要的。平时饮食要多加注意,以清淡为宜,增加适当的运动,对身心健康都有很大益处。如有异常情况发生,要及时就医,以免耽误治疗。
孕期可以性生活吗? 孕期性生活该注意什么 怀孕期间往往要注意很多事情,那么孕期可以性生活吗?孕期性生活的好处[详情]
女人宫寒易造成不孕 宫寒怎么解决? 宫寒也就是子宫寒冷,子宫需要温暖,温煦的环境才能健康的,才能正常发挥功能。[详情]
想要肝脏排毒吃这些!帮助体内毒物的排泄,促进机体的正常代谢 肝脏排毒吃什么,下面一起来看看吧。 绿豆 [详情]
为什么会口臭? 两招自我检测有没有口臭? 口气重是什么原因,下面一起来看看吧。 口腔卫生不好,常会导致牙菌斑[详情]
春节后糖尿病人如何通过运动来让自己的血糖稳定 随着春节的过去,很多人开始恢复自己正常的工作和生活,而大多数[详情]